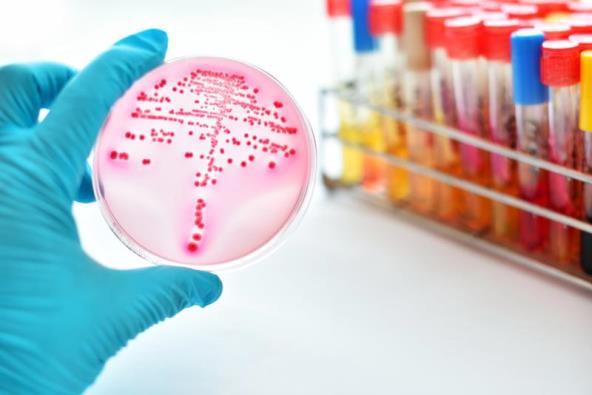

Podsetimo, još pre dve godine stručnjaci su počeli da predviđaju pojavljivanje supergonoreje koja će biti otporna na sve poznate načine lečenja.
Čovek koji se zarazio ovom polno prenosivom bolešću rekao je lekarima da su mu se prvi simptomi gonoreje pojavili pre par meseci, nakon što je imao seks sa ženom u stranoj zemlji. Međutim, iz do sada dostupnih podataka, ne zna se da li je supergonoreju dobio od žene, ili je bakterija mutirala u njemu. U svakom slučaju, nakon što je otišao kod lekara, dobio je recept za ceftriakson i spektomicin, međutim, bakterija mu je ostala u grlu, što znači da terapija nije uspela.
Nakon toga poslat je na laboratorijske pretrage gde je utvrđena rezistencija na azitromicin i ceftriakson. Terapija je eventualno bila moguća spektomicinom.
Pacijent će biti podvrgnut sredinom aprila ponovnom testiranju kako bi se utvrdilo da li je ovog puta gonoreja izlečena - trenutno je na terapiji koja uključuje jednu injekciju dnevno ertapanema.
Koji su simptomi gonoreje?
Gonoreja je jedna od podmuklijih polnih bolesti čiji simptomi dugo mogu da prođu nezapaženo.
Zdravlje žene: Ginekološki problemi na koje moramo obratiti pažnju
Kod žena, simptomi uključuju:
- Neobičan vaginalni sekret, koji može biti i vrlo slab i vodenast, ili čak i gust i zelene boje.
- Peckanje i bol prilikom mokrenja.
- Bol ili bilo kakav čudan osećaj u predelu donjeg stomaka (ovo je jedan od ređih simptoma).
- Krvarenje između menstruacija, promena u tome koliko je obilna menstruacija i krvarenje nakon seksa.
Kod muškaraca, simptomi mogu da budu sledeći:
- Neobičan sekret iz penisa, koji može da bude i beo, ali i žut ili zelen.
- Bol i peckanje prilikom uriniranja.
- Upala ili otok kožice.
- Bol u testisima (što je redak simptom).